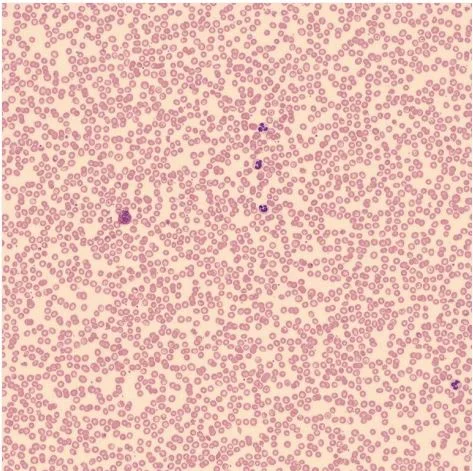
Adult stem cells

NOW LEGAL IN FLORIDA PURSUANT TO SB1768
Feel Better Now
Future Proof Yourself
STEM CELL THERAPY
For years, Dr. Nina Gupta, MD ABAARM FAARM – with 37 years under her belt – has focused
on stem cell therapy. Her credentials include training and accreditation from the American
Academy of Stem Cell Physicians, plus a board certification in Anti-Aging & Regenerative
Medicine. The practice follows every rule set by Florida’s Law SB1768, making sure all work
with stem cells meets strict guidelines. Cells come straight from a medical facility approved by
the FDA, where growth takes place using GMP-defined methods. Research there has long
centered on stem cells, now at a quarter century. All cells are NOT created equal.
Healing can come through stem cells when they help the system work better on its own. Done
right in an office setting without surgery, patients meet and get treated by Dr. Nina Gupta, MD
face to face during treatment. Each person gets a custom approach because needs differ widely
from one another.
What makes Celgevity different from other stem cell products? Celgevity uses a birth
tissue-sourced regenerative medical product.
When Compared to Autologous Stem Cell Sources (using a person’s own fat, bone marrow or
blood, etc.), Celgevity cells are:
• Obtained from healthy newborn babies born in continental U.S.
• Cells are more primitive, metabolically more active, with faster rate of self renewal, and wider
range of differentiation, Secrete more growth factors, have longer telomeres, senesce (get old)
slower, and there is a lack of accumulation of lifelong cellular damages of adult stem cells,
which have gone through oxidative stress, radiation, or other toxic exposures associated with
living and aging.
• Highly rich in cytokines & growth factors, many of which are no longer present in adult tissue
sources.
• Have more anti-inflammatory and neuro-protective effects.
• Using CELGEVITY products avoids invasive procedures involved in autologous stem cell
harvesting, thus avoiding the risks of infection, scarring, and decline in a person’s own stem cell
pool.
• Even someone who is more advanced in age or more ill can obtain high quality stem cells to
help their body heal and regenerate.
• Allows for repeated dosing at precise concentrations in regular intervals to target various
conditions.
• CELGEVITY products are processed in a FDA-registered and inspected laboratory that
adheres to cGMP guidelines, which means it provides much more quality assurance compared
to the tissue-processing in a physician’s office.
EXOSOME THERAPY
WHAT ARE EXOSOME STEM CELLS?
Small packages carry big signals – exosomes, shed by stem cells, deliver key details to nearby
tissue. Carrying genetic material, along with active molecules like proteins and triggers for
growth, they help cells talk. Repair work in damaged areas often gets a boost from these natural
signals. Found in umbilical cord sources, these particles pull healing forces into action. Repair
gets a boost because umbilical cord stem cells release useful particles. Healing shows signs of
support when these tiny deliveries reach nearby cells. Full of growth factors and healing
proteins, they calm swelling while helping cells fix injuries. Since these helpful molecules reach
injured spots, exosomes help bodies bounce back – offering a reliable way to manage several
health situations without causing harm. What makes exosome stem cells so effective is what
they contain: cytokines along with microRNAs. Ligaments might recover faster when exosomes
step in. Tendons too, along with cartilage, find support through these tiny particles. Healing
stubborn wounds? They lend a hand there as well. Even sudden injuries may find smoother
paths forward thanks to what these vesicles carry.
What is a Stem Cell ?
Our body is made up of many different types of cells.
● Most cells are ‘specialized’, meaning they perform different functions.
For example, red blood cells are specialised to carry oxygen around
the body in the blood, while some gut cells are specialized to absorb
nutrients from food.
● All specialized cells start out as stem cells – the foundation for every
organ and tissue in the body. They provide new cells for the body as
it grows and replace specialized cells as they get older or damaged.
● Stem cells are defined by two unique properties:
● They can divide over and over again to produce new stem cells.
● As they divide, they can change into the other types of cell that
make up the body.
There are three main types of stem cells:
Embryonic stem cells

which supply new cells for an
embryo as it grows and develops into a baby
Embryonic stem cells are ‘pluripotent’, which means they can change
into any cell in the body.
Adult stem cells
which replace old or damaged cells
Adult stem cells are ‘multipotent’, which means they can only change
into some cells in the body not all cell types. This is because they
have already started to specialise, so can only develop further into a
specific type of cell.
For example, blood (or ‘haematopoietic’) stem cells can only replace
the various types of cells in the blood. Skin (or ‘epidermal’) stem cells
can replace the different types of cells that make up our skin and hair.
Induced pluripotent stem cells (or ‘iPS cells’) are
made in the laboratory

Normal adult cells (often skin cells) can be reprogrammed in the lab to
become stem cells. This is called ‘inducing’ the stem cells.
Just like embryonic stem cells, they are pluripotent so can,
theoretically, develop into any cell type.
Stem cells have the potential to treat different conditions in
medicine. We use Stem Cell Therapy for pain management and
orthopedic purposes as dictated by Florida law